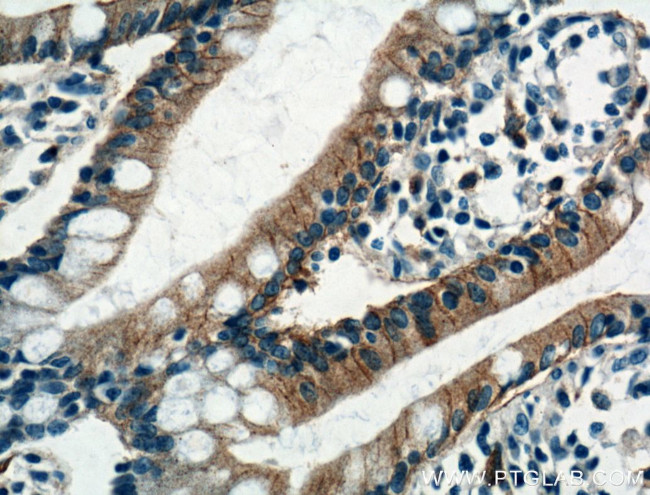
GLUT2 Antibody in Immunohistochemistry (Paraffin) (IHC (P))
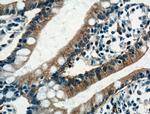
GLUT2 Antibody in Immunohistochemistry (Paraffin) (IHC (P))

Search
Proteintech
GLUT2 Polyclonal Antibody
{{$productOrderCtrl.translations['antibody.pdp.commerceCard.promotion.promotions']}}
{{$productOrderCtrl.translations['antibody.pdp.commerceCard.promotion.viewpromo']}}
{{$productOrderCtrl.translations['antibody.pdp.commerceCard.promotion.promocode']}}: {{promo.promoCode}} {{promo.promoTitle}} {{promo.promoDescription}}. {{$productOrderCtrl.translations['antibody.pdp.commerceCard.promotion.learnmore']}}
产品信息
20436-1-AP
种属反应
已发表种属
宿主/亚型
分类
类型
抗原
偶联物
形式
浓度
规格
纯化类型
保存液
内含物
保存条件
运输条件
产品详细信息
This antibody detected 60-70 kDa fully glycosylated, matured GLUT2 and a nonglycosylated form of GLUT2 around 38-45 kDa.
Immunogen sequence: SPRYLYIKL DEEVKAKQSL KRLRGYDDVT KDINEMRKER EEASSEQKVS IIQLFTNSSY R (69-128 aa encoded by BC060041)
靶标信息
Glucose transporter 2 isoform is an integral plasma membrane glycoprotein of the liver, islet beta cells, intestine, and kidney epithelium. It mediates facilitated bidirectional glucose transport. Because of its low affinity for glucose, it has been suggested as a glucose sensor. Mutations in the gene that encode this protein cause Fanconi-Bickel syndrome.
仅用于科研。不用于诊断过程。未经明确授权不得转售。
生物信息学
蛋白别名: glucose transporter 2; Glucose transporter type 2, liver; glucose transporter-like protein; GLUT-2; liver-type glucose transporter; solute carrier family 2 (facilitated glucose transporter), member 2; Solute carrier family 2, facilitated glucose transporter member 2; unnamed protein product
基因别名: AI266973; Glut-2; GLUT2; GTT2; SLC2A2
UniProt ID: (Human) P11168, (Mouse) P14246
Entrez Gene ID: (Human) 6514, (Mouse) 20526, (Rat) 25351